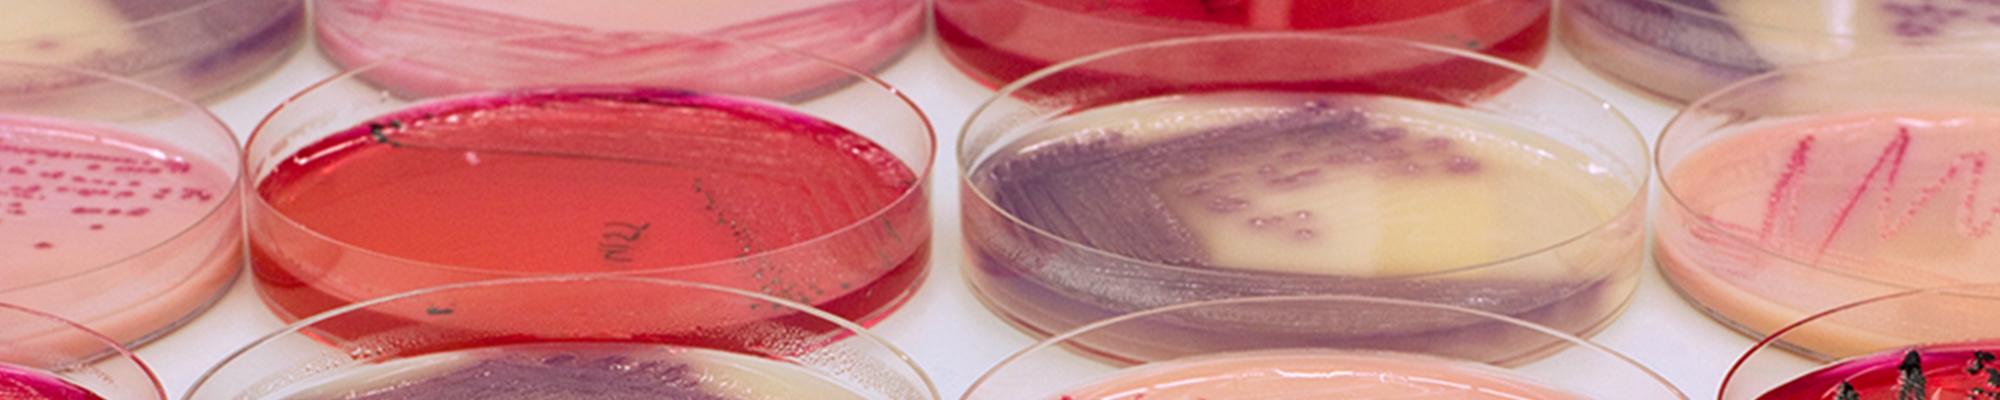

01/04/25
On Tuesday, April 8 and April 15, from 1 pm to 3 pm, ‘Conèixer els màsters’ will take place at the Blasco Ibáñez and Burjassot campuses, respectively. The initiative, which aims to provide first-hand information about the official master's degree studies of the Universitat de València to interested...